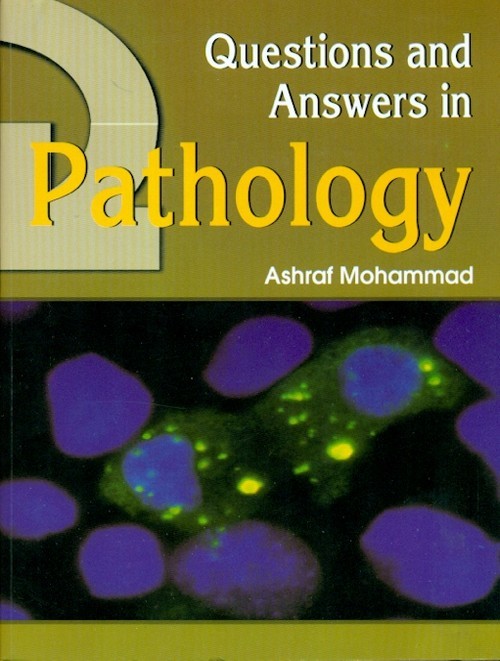
Questions and answers in pathology

. These phenomena are described in Section 1 in Chapters 1 to 4 as: Cell Injury Inflammation and Repair Disorders of the Immune System Neoplasm/Neoplasia. Disorders pertaining to the blood flow (haemodynamic disorders) are described in Chapter 5. Applications of these fundamental facts to the various systems of our body are described in Section 2 in Chapters 8 to 18 as HS CVS RS GIS US NS ES REP. S MSS Skin and E & E. The book aims to serve the undergraduate medical students in revising the course material and appearing in their examinations with full knowledge and confidence.
| Specifications | Descriptions |
|---|---|
| ISBN | 9788123918570 |
| Published Year | 2012 |
| Binding | Paperback |
| Subject | Pathology |
| Pages | 417 |
| Weight | 0.5 (In Kg) |
| Readership | MBBS Second Year |
Your experience on this site will be improved by allowing cookies.